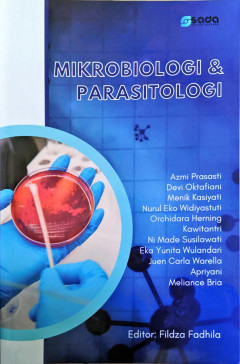
cover

Ditapis dengan
Ditemukan 2 dari pencarian Anda melalui kata kunci: author=Eka Yunita Wulandari
Pengantar Mikrobiologi
- Edisi
- -
- ISBN/ISSN
- 978-623-8385-11-9
- Deskripsi Fisik
- 236 hlm.
- Judul Seri
- -
- No. Panggil
- 576 ULI p
- Edisi
- -
- ISBN/ISSN
- 978-623-8385-11-9
- Deskripsi Fisik
- 236 hlm.
- Judul Seri
- -
- No. Panggil
- 576 ULI p
Mikrobiologi dan Parasitologi
- Edisi
- -
- ISBN/ISSN
- 978-623-09-2658-7
- Deskripsi Fisik
- vii, 146 hlm., 15,5 x 23 cm.
- Judul Seri
- -
- No. Panggil
- 616.96 FIL m
- Edisi
- -
- ISBN/ISSN
- 978-623-09-2658-7
- Deskripsi Fisik
- vii, 146 hlm., 15,5 x 23 cm.
- Judul Seri
- -
- No. Panggil
- 616.96 FIL m
 Karya Umum
Karya Umum  Filsafat
Filsafat  Agama
Agama  Ilmu-ilmu Sosial
Ilmu-ilmu Sosial  Bahasa
Bahasa  Ilmu-ilmu Murni
Ilmu-ilmu Murni  Ilmu-ilmu Terapan
Ilmu-ilmu Terapan  Kesenian, Hiburan, dan Olahraga
Kesenian, Hiburan, dan Olahraga  Kesusastraan
Kesusastraan  Geografi dan Sejarah
Geografi dan Sejarah